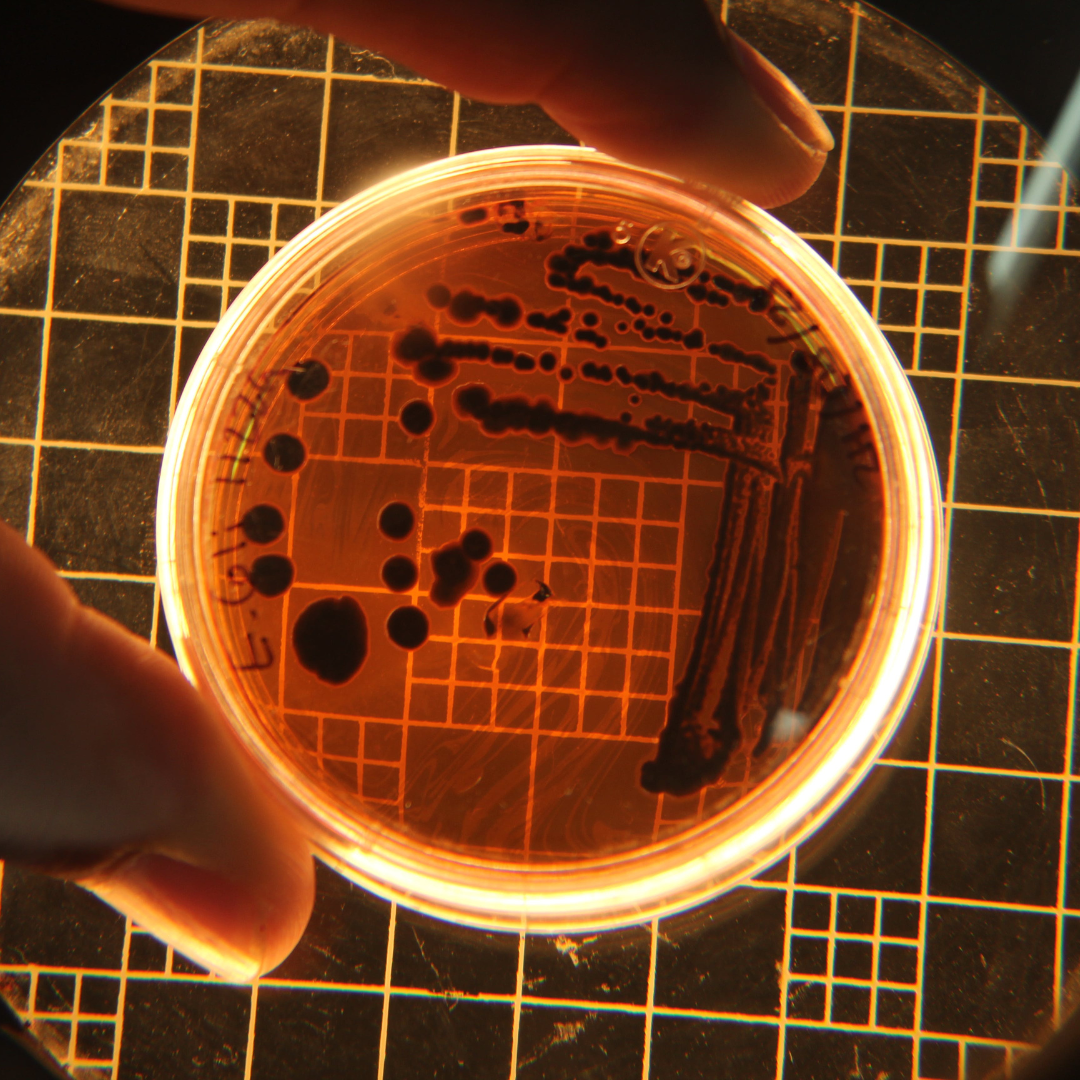

Your Trusted Partner In Healthcare And Laboratory Solutions.
If you are looking for a reliable partner to meet your clinical diagnostics and laboratory needs, you’ve come to the right place. At SK Trading Corporation, we provide high-quality solutions to take your healthcare services to the next level..
WHAT WE HAVE
KNOW OUR PRODUCTS
WHO ARE WE
ABOUT US
At SK Trading Corporation, we are committed to delivering high-quality and cost-effective solutions for clinical diagnostics and laboratory requirements. Under one roof, we provide an extensive range of clinical diagnostic kits, reagents, laboratory instruments, blood bank equipment, culture media, consumables, plasticware, and glassware.
Our dedication goes beyond offering dependable products—we prioritize our customers because we care deeply about human lives. By maintaining exceptional quality and personalized support, we aim to be a trusted partner in advancing healthcare and diagnostics.

WHATS NEW
NEW ARRIVALS
NEED TO KNOW ABOUT
FAQ
Why choose SK Trading Corporation?
We have been serving the healthcare and laboratory industry since 1990, providing high-quality instruments, diagnostic reagents, and laboratory solutions. Our long-standing reputation, professional team, and reliable after-sales support make us a trusted partner for research and diagnostics.
How do I choose the right product for my needs?
If you are unsure, our team of experts can guide you based on your laboratory’s requirements. Simply reach out to our sales or support team, and we will recommend the most suitable options.
How can I place an order?
Orders can be placed via email or by directly contacting our sales department. Once confirmed, our team ensures timely processing and delivery.
Do you provide technical support for your products?
Yes. Our qualified service team offers full technical support, from installation to troubleshooting, ensuring that your equipment and reagents perform efficiently.
Do you offer after-sales service and maintenance?
Absolutely. We provide reliable post-maintenance services to ensure the long-term performance and accuracy of your instruments.
Who do you serve?
We cater to a wide range of clients, including pharmaceutical companies, diagnostic centers, research laboratories, and institutions in the life sciences sector.